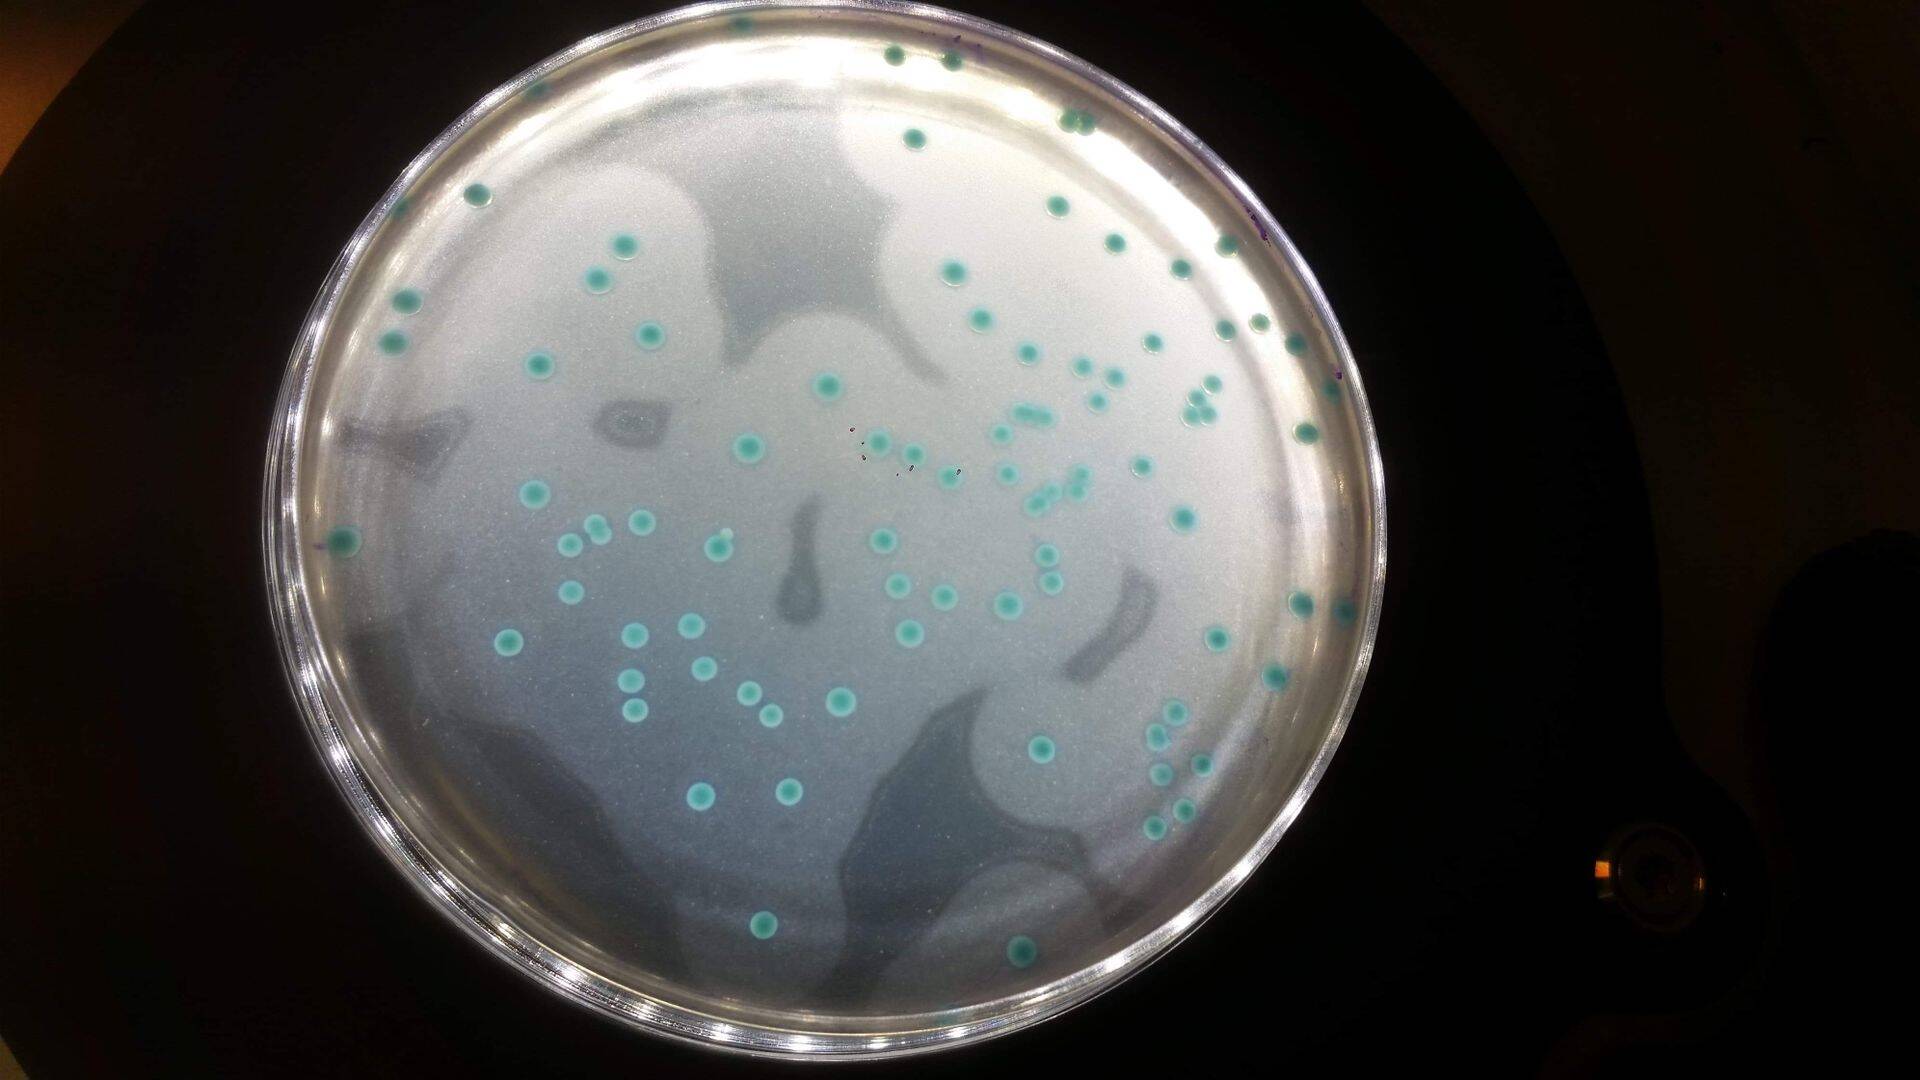
Listeria monocytogenes. Listerioos on üks ohtlikematest toidunakkustest ja võib nõrgestatud immuunsüsteemi korral põhjustada isegi surma

Inimese keha on superorganism, mis koosneb triljonitest inimrakkudest ja vähemalt sama paljudest mikroobirakkudest. Inimeses elavad ja tegutsevad mikroorganismid (bakterid, pärmid, arhed, viirused) moodustavad meie mikrobioomi. Need mikroskoopilised kaaslased elavad nahal, limaskestadel, aga suurem osa soolestikus.
- Listeria monocytogenes. Listerioos on üks ohtlikematest toidunakkustest ja võib nõrgestatud immuunsüsteemi korral põhjustada isegi surma
Täiskasvanud inimese keha võib sisaldada kuni 3 kg mikroobe. Soolestiku mikrobioomi tegevus mõjutab meie tervist. Soolestiku mikroobid on meie elus väga vajalikud, lagundades toitaineid, tootes vitamiine (K ja B) ja isegi n-ö õnnemolekule dopamiini, serotoniini. Mikrobioomi muutused võivad põhjustada põletikke, autoimmuunhaigusi ja isegi psüühikahäireid.
Kas me saame mõjutada soolestiku mikrobioomi?
Inimese individuaalne mikrobioom saab alguse sünniga ja kujuneb lapseeas. Mikrobioomi kooslusesse kuuluvad nii püsiresidendid kui ka nn muutuv koosseis. Elu jooksul mõjutavad seda elustiil, vanus ja elukeskkond. Kõige enam mõjutab mikrobioomi toit, mille toime võib avalduda kolmel moel:
• Toiduga lisanduvad mikroobid tõstavad soolestiku mikrobioomi mitmekesisust ja heade mikroobide osakaalu.
• Toidust põhjustatud häired mikroobikoosluses parandatakse kiiresti ja saavutatakse uuesti mikrobioomi stabiilsus. Mida mitmekesisem on mikroobikooslus, seda stabiilsem on meie mikrobioom.
• Toidus leiduvad patogeenid (nt Salmonella) või tinglikud patogeenid (nt Listeria monocytogenes) rikuvad mikrobioomi tasakaaluseisundi. Mikroobse mitmekesisuse vähenemine ja nn halbade mikroobide osakaalu suurenemine põhjustab haigestumist.
Mida teha, et toit meie mikrobioomi ei kahjustaks?
Kontrollige toidu mikrobioloogilist kvaliteeti! Icosagen ASi mikrobioloogia labor töötab standardis ISO 17025 katselaboritele kehtestatud nõuete kohaselt. Enim kasutatavad analüüsimeetodid on akrediteeritud Eesti Akrediteerimiskeskuse poolt.
Määrame toidust:
• patogeenide esinemist;
Kõige sagedasemateks bakteriaalseteks toidunakkuste tekitajateks on
Campylobacter jejuni ja
Salmonella spp. Terviseameti andmed näitavad, et salmonelloosi haigestumine on viimase 4 aasta jooksul suurenenud mitu korda (
terviseamet.ee).
• tinglike patogeenide esinemist;
Valmistoitudest on väga oluline kontrollida
Listeria monocytogenes’e esinemist, mis nõrgestatud immuunsüsteemiga inimestel (lastel, vanuritel, rasedatel, immuunpuudulikkusega haigetel) võib põhjustada listerioosi. Listerioos on väga ohtlik toidunakkus, sest suremus haigusesse on väga kõrge (20-30%). 2018. aastal haigestus Eestis listerioosi 28 inimest (
terviseamet.ee) ja kahjuks on esinenud mitmeid surmajuhtumeid.
Sageli määratakse arvuliselt baktereid Clostridium perfringens, Bacillus cereus ja Staphylococcus aureus, mis samuti võivad põhjustada haigestumist.
• indikaatorbaktereid;
Headest tootmistavadest kinnipidamise ja hügieeni kontrollimiseks sobivad enterobakterite, coli-laadsete bakterite ja Escherichia coli arvukused.
• toidu säilimisaega.
Toidu säilitamisel mikroobide arv kasvab, mistõttu on oluline määrata selle säilimisaeg. Riknemisega korreleeruvad mikroobide üldarv, Listeria monocytogenes’e, hallituste ja pärmide arvukus.
Kontrollige toitu akrediteeritud laboris, sest ohutu toit on meie elukindlustus!
Lisainfot vaata
icosagen.ee